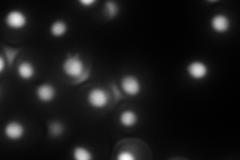
YMR039C
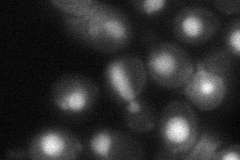
YMR039C
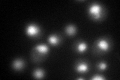
YMR039C
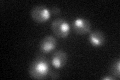
YMR039C

View description
Transcriptional coactivator, facilitates elongation through factors that modify RNAP II; role in peroxide resistance involving Rad2p; role in the hyperosmotic stress response through polymerase recruitment at RNAP II and RNAP III genes
Localization:
Intensity:
Fold change:
Significance:
-
C’ GFP library in SD

nucleus44.83 -
N' NOP1pr-GFP in SD

nucleus140.062 -
N' TEF2pr-mCherry in SD
nucleus265.913 -
N' NATIVEpr-GFP in SD

nucleus65.6076 -
N' TEF2pr-VC and Cyto-VN in SD
nucleus45.058 -
C’ GFP library in SD+DTT
nucleus61.161.36Yes -
C’ GFP library in SD+H2O2
nucleus45.851.02No -
C’ GFP library in Starvation Media

nucleus39.590.88No -
C’ GFP library on the background of Pup2-DaMP

nucleus -
C’ GFP library on the background of CCT mutant

nucleus37.85390.844248No
